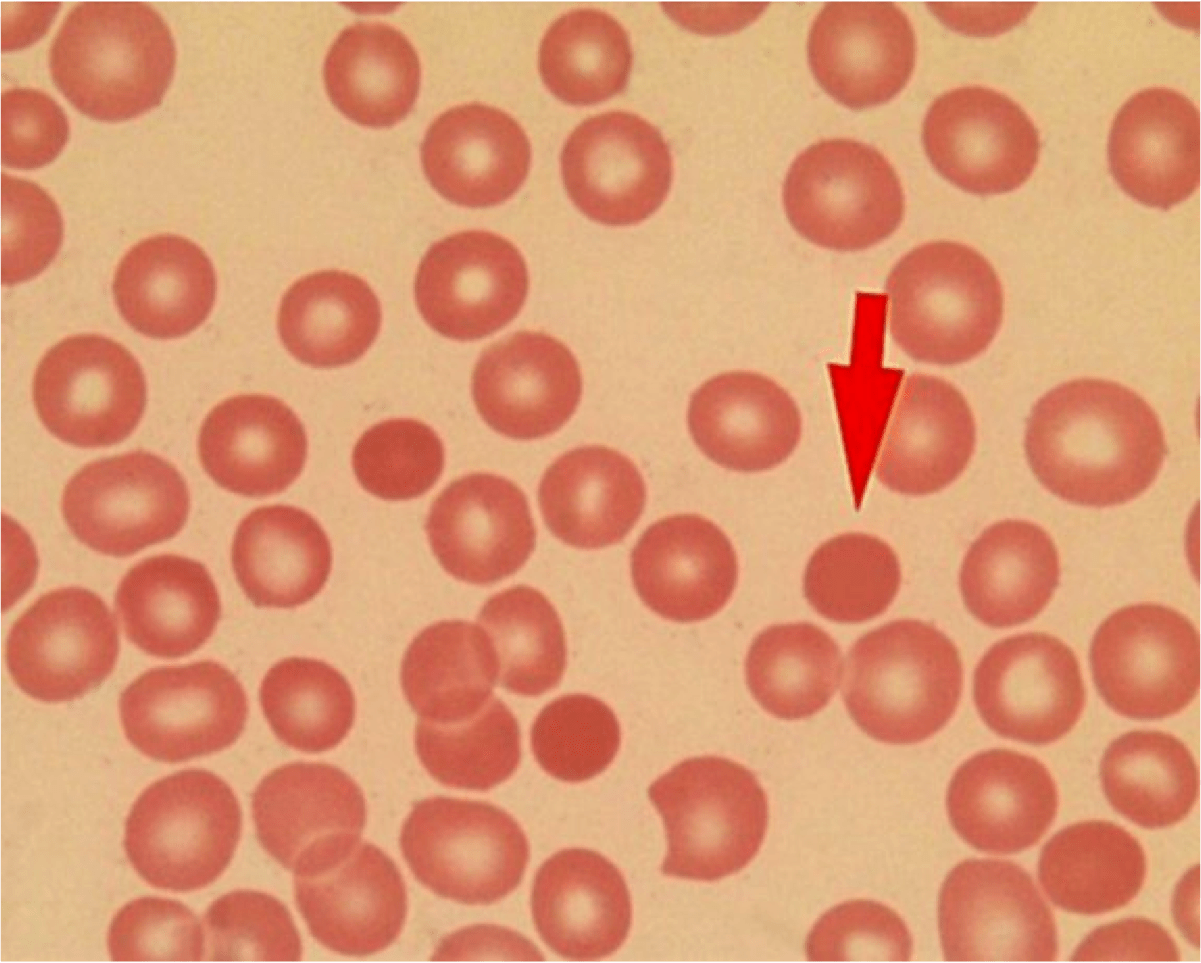

Микросфероцитоз это
Дидактические игры способствуют развитию познавательных и
Пизанская башня 5
Лом и отходы полиэтилена
15000 0 15
Инновационные региональные практики
Carel mini инструкция
North face производитель
Продуктивные и негативные симптомы и синдромы
Алгебра 9 класс номер 108 стр 42
Каратэ кендо
Т банк отзывы сотрудников удаленно
Григ с добрым утром
Время нагрева нагревателя
Микросфероцитоз это 117 фотографий